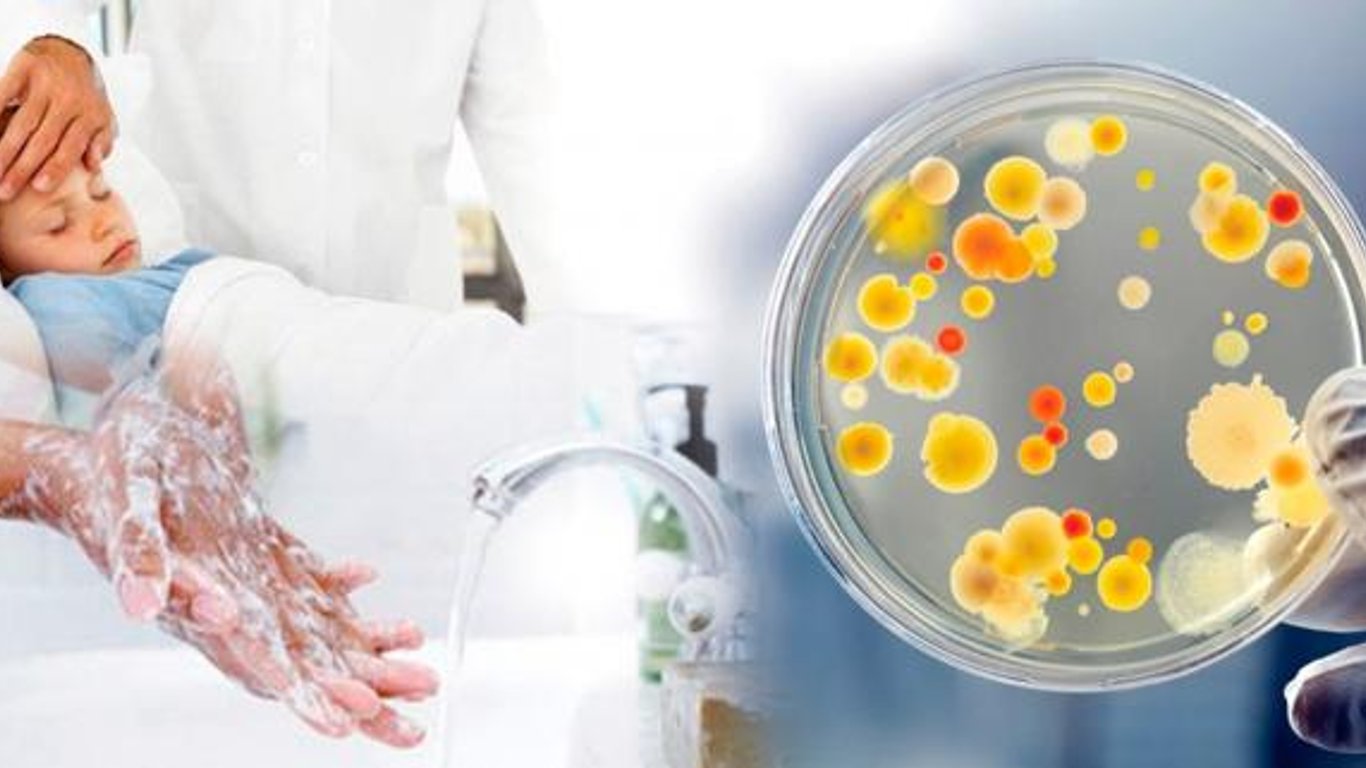

Їли немиті овочі та молочні продукти з ринку: в Одесі виявили 78 людей з гострою кишковою інфекцією
В Одесі у 78 людей виявили гостру кишкову інфекцію. Серед захворілих – 42 % дітей, віком до 17 років.
Про це повідомляє пресслужба Одеської міської ради.
Читайте також: В Одесі чоловік заморив голодом свого сина
Минулого тижня в Одесі зареєстровані 78 випадків гострих кишкових інфекцій, з яких 42 % склали діти у віці до 17-ти років, 58 % – доросле населення.
Згідно з факторним аналізом, більшість випадків захворювань пов'язана із вживанням готових домашніх страв з порушенням технології приготування і зберігання, немитих овочів і фруктів, молочних і м'ясних продуктів, придбаних на стихійних ринках.
У міськраді також додоли, що захворюваність на ГРВІ та грип в Одесі минулого тижня знизилася на 11,2 %, порівняно з попереднім тижнем, і склала 1717 випадків, з яких 74,6 % – діти.
"Рівень захворюваності на ГРВІ та грип в Одесі знаходиться в три рази нижче за епідемічний поріг і відповідає сезонному рівню для цієї пори року. Згідно з вірусологічним моніторингом, спостерігається циркуляція вірусів негрипозної природи (парагрип, метапневмовірус)", – додали у пресслужбі.
Вірусні гепатити та повітряно-крапельні інфекції реєструвалися поодинокими випадками. Випадки дифтерії, кору, краснухи, епідемічного паротиту не зареєстровані.
Нагадаємо:
- Санепідситуація в Одеській області станом на 9 липня характеризується як напружена. За період поточного року зареєстровано 10 спалахів гострих кишкових інфекцій.
Більше оперативних новин шукайте в Telegram і Viber Новини.LIVE.